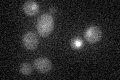
YKL185W
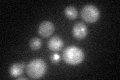
YKL185W
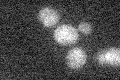
YKL185W

View description
Zinc-finger inhibitor of HO transcription; mRNA is localized and translated in the distal tip of anaphase cells, resulting in accumulation of Ash1p in daughter cell nuclei and inhibition of HO expression; potential Cdc28p substrate
Localization:
Intensity:
Fold change:
Significance:
-
C’ GFP library in SD
nucleus18.43 -
N' NOP1pr-GFP in SD

nucleus31.9087 -
N' TEF2pr-mCherry in SD

nucleus10.1719 -
N' NATIVEpr-GFP in SD

nucleus25.344 -
N' TEF2pr-VC and Cyto-VN in SD

below threshold25.0711 -
C’ GFP library in SD+DTT
nucleus19.041.03No -
C’ GFP library in SD+H2O2

nucleus21.471.16No -
C’ GFP library in Starvation Media
nucleus14.760.8No -
C’ GFP library on the background of Pup2-DaMP

nucleus -
C’ GFP library on the background of CCT mutant

nucleus18.59571.00804No
